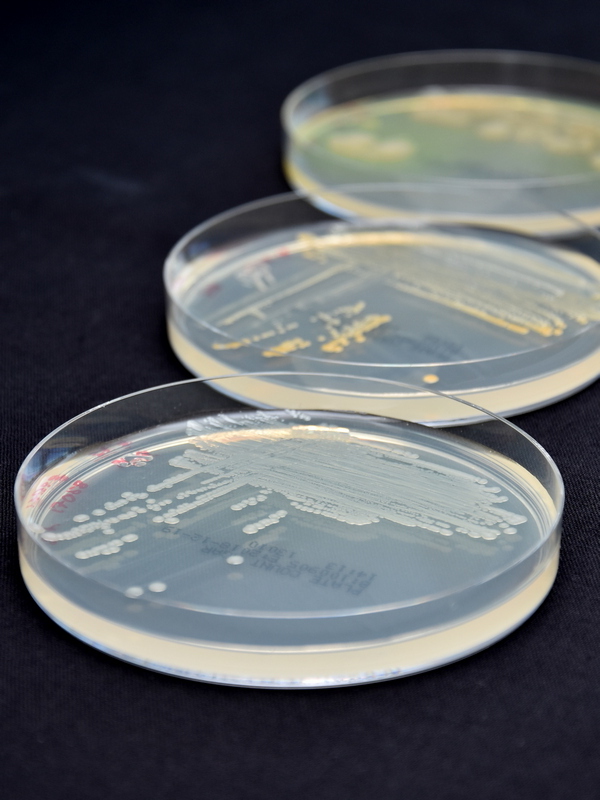

Our laboratory supports many customers around the world in a wide variety of market segments with analyses and services.

The laboratory has a large collection of strains of bacteria, yeasts and fungi:
– human and animal pathogenic infectious bacteria
– clinical isolates from infected patients
– multi-resistant variants, e.g. MRSA, MRSE, VRE, MRGN, etc.
– Isolates from volunteers and contaminated production facilities
– current critical germs in the world
– Microorganisms of the skin microbiome
– Microorganisms from the field of agriculture
– Fungi from inside and outside of buildings

The medical field includes a large portfolio of methods to assess the safety of medical devices, including e.g.:
– antimicrobial efficacy studies
– Biofilm formation on the surface
– Bioburden
– Blood retention
– Microbial tightness in contaminated atmosphere
– Microbial tightness when handling the devices
– Chemical tightness of infusion systems
– simulated in-use tests under application-specific conditions
– Release studies of active ingredients
– Investigations into the kinetics of action over time
– and many more ….

The following focal points of examination are offered for cosmetics:
– Skin microbiome compatibility for leave-on and rinse-off products
– Differential growth kinetics
– Bacteriocin detection
– UVA/UVB irradiation test on skin microbiome organisms
– Vegan skin microbiome compatibility test for vegan cosmetics
– Surface Protection Test for antimicrobial cosmetics
– Investigations into the kinetics of action over time
– and many more ….

The Coatings area includes a large portfolio of methods for testing paints, varnishes and coatings of all kinds, including e.g.:
– antimicrobial efficacy studies
– microbial adhesion on the surface
– Biofilm formation on the surface
– simulated in-use tests under application-specific conditions
– Investigations into the kinetics of action over time
– and many more ….

The following microbiological tests are offered in the polymer area:
– antimicrobial efficacy studies
– microbial adhesion on the surface
– Biofilm formation on the surface
– simulated in-use tests under application-specific conditions
– Release studies of active ingredients
– Investigations into the kinetics of action over time
– and many more ….

The Textiles division examines various microbiological aspects, including e.g.:
– antimicrobial efficacy studies
– microbial adhesion on the surface
– Biofilm formation on the surface
– Efficiency of bacterial reduction surface cleaning
– simulated in-use tests under application-specific conditions
– Investigations into the kinetics of action over time
– and many more ….

In the area of hygiene, various aspects can also be examined, including e.g.:
– Efficacy studies of disinfectants
– Resistance formation studies
– Investigations into the kinetics of action over time
– Efficiency of bacterial reduction surface cleaning
– Air and surface contamination
– and many more ….

In the field of agriculture, investigations are carried out in both plant cultivation and animal husbandry, including e.g.:
– Efficacy studies of products against certain pathogens
– Resistance formation studies
– Investigations into the kinetics of action over time
– and many more ….